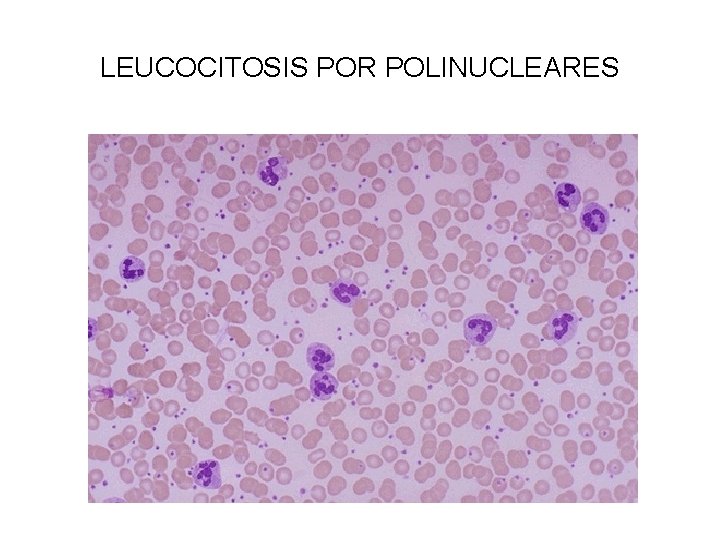
LEUCOCITOSIS POR POLINUCLEARES

ANATOMA PATOLGICA GENERAL 3 CURSO 2010 INFLAMACIN AGUDA

- Slides: 40
ANATOMÍA PATOLÓGICA GENERAL 3º CURSO. 2010 INFLAMACIÓN AGUDA
INFLAMACIÓN AGUDA. CAMBIOS VASCULARES I • I. -FLUJO Y CALIBRE VASCULAR • VASODILATACIÓN = AUMENTO DEL FLUJO SANGUINEO QUE CAUSA CALOR Y ERITEMA. MEDIADORES ( HISTAMINA Y ÁCIDO NÍTRICO) • II. -AUMENTO DE LA PERMEABILIDAD • SALIDA DE LÍQUIDO RICO EN PROTEINAS. . AUMENTO DE LA PRESIÓN ONCÓTICA INTERSTICIAL Y DISMINUCIÓN DE LA HIDROSTÁTICA VASCULAR CAUSAN EL EDEMA (TUMOR) • ESTASIS DE HEMATIES POR PÉRDIDA DE LÍQUIDOS (SLUGE) QUE CURSA CON AUMENTO DE LA VISCOSIDAD SANGUINEA Y DISMINUCIÓN DE LA VELOCIDAD DE CIRCULACIÓN. LOS POLINUCLEARES SE MARGINAN Y SE ADOSAN AL ENDOTELIO Y SALEN AL INTERSTICIO (DIAPEDESIS)
INFLAMACIÓN AGUDA MARGINACIÓN LEUCOCITARIA
INFLAMACIÓN AGUDA CAMBIOS VASCULARES II • MECANISMOS DE AUMENTO DE LA PERMEABILIDAD VASCULAR • 1º. -HIATOS ENDOTELIALES EN LAS VÉNULAS: MEDIADOS POR LA • HISTAMINA Y LEUCOTRIENOS. RÁPIDA, REVERSIBLE Y DE VIDA CORTA (1530´). 2º. -AGRESIÓN DIRECTA DEL ENDOTELIO: QUEMADURAS, BACTERIAS NECROTIZANTES. AFECTA VÉNULAS, ARTERIOLAS Y CAPILARES. RÁPIDA DURA HORAS O DÍAS. PUEDE HABER ADESIÓN PLAQUETARIA Y TROMBOSIS. • 3º. -LESIÓN ENDOTELIAL POR LEUCOCITOS : SE DA EN VÉNULAS, , CAPILARES PULMONARES Y GLOMERULARES. TARDÍA Y DE LARGA DURACIÓN. • 4º. - AUMENTO DE LA TRANSCITOSIS: ORGANELAS VESICOVACUOLARES CERCA DE LAS UNIONES INTERCELULARES. (VEGF) • 5º. -FORMACIÓN DE VASOS NUEVOS: ANGIOGÉNESIS, AUMENTO DE LA PERMEABILIDADQUE PERSISTE HASTA LA MADURACIÓN DES LAS CÉLULAS ENDOTELIALES. (VEGF ETC. . )
INFLAMACIÓN AGUDA CAMBIOS CELULARES • 1º. - MARGINACIÓN, RODADURA Y ADHESION LEUCOCITARÍA: COMO CONSECUENCIA DEL ESTASIS. • 2º. -ADHESIÓN Y TRANSMIGRACIÓN LEUCOCITARIA: LA ADHESIÓN ESTA REGULADA POR LAS SELECTINAS, INMUNOGLOBULINAS, INTEGRINAS Y GLUCOPROTEINAS (MUCINA) • 3º. - MIGRACIÓN INTERSTICIAL (QUIMIOTAXIS): PRODUCTOS EXÓGENOS BACTERIANOS( N-FORMIL-METIONINA) Ó ENDÓGENOS( SISTEMA DEL COMPLEMENTO- C 5 a, LEUCOTRIENOS, CITOCINAS) • 4º. - ACTIVACIÓN DE LOS LEUCOCITOS: PRODUCIÓN DE METABOLITOS DE ÁCIDO ARAQUIDÓNICO POR ACTIVACIÓN DE LA FOSFOLIPASA A 2. . DEGRANULACIÓN Y SECRECIÓN DE ENZIMAS. SECRECIÓN DE CITOQUINAS. • 5º. - FAGOCITOSIS: RECONOCIMIENTO-UNIÓN, INTERIORIZACIÓN (OPSONINAS), MUERTE O DEGRADACIÓN • 6º. - LIBERACIÓN DE ENZIMAS LISOSOMALES: DAÑO TISULAR: GLOMERULONEFRITIS, ASMA, SHOCK SÉPTICO, VASCULITIS, RECHAZO, ETC.
MEDIADORES QUÍMICOS EN LAS REACCIONES DE LA INFLAMACIÓN AGUDA 1º. - VASODILATACIÓN : PROSTAGLANDINAS, ÓXIDO NÍTRICO. HISTAMINA. 2º. - AUMENTO DE LA PERMEABILIDAD VASCULAR : SEROTONINA, COMPLEMENTO (C 3 a Y C 5 a), KININAS ( BRADIKININA- Cascada activada por el factor XII a de la coagulación), LEUCOTRIENOS (C 4, D 4, E 4) , PAF( Factor activador de las plaquetas) 3º. - QUIMIOTAXIS Y ACTIVACIÓN LEUCOCITARIA : C 5 a (PMN, MONOCITOS Y BASÓFILOS). LEUCOTRIENO B 4, QUIMIOCINAS, IL-1 (Interleucina), TNF( factor de necrosis tisular), PRODUCTOS BACTERIANOS 4º. - FIEBRE : IL-1. TNF. PROSTAGLANDINAS. 5º. - DOLOR : PROSTAGLANDINAS. BRADICININA. 6º DAÑO TISULAR : ENZIMAS LISOSOMALES DE LOS POLIMORFONUCLEARES Y MACROFAGOS. ÓXIDO NÍTRICO. 7º. -TRATAMIENTO CON ANTIINFLAMATORIOS: ESTEROIDES, ASPIRINA
RESULTADOS DE LA INFLAMACIÓN AGUDA
RESULTADOS DE LA INFLAMACION AGUDA • 1. - RESOLUCION COMPLETA : IMPLICA LA NEUTRALIZACIÓN COMPLETA E ELIMINACIÓN ESPONTÁNEA DE LOS MEDIADORES QUÍMICOS CON LA VUELTA A LA PERMEABILIDAD VASCULAR NORMAL, CESE DEL INFILTRADO DE LEUCOCITOS Y ELIMINACIÓN DE DETRITUS, EDEMA, PROTEINAS Y AGENTES EXTRAÑOS DEL FOCO DE INFLAMACIÓN. • 2. - CURACIÓN CON REEMPLAZAMIENTO DE TEJIDO CONECTIVO: TEJIDO DE GRANULACIÓN. ORGANIZACIÓN DEL EXUDADO- FIBROSIS (CICATRIZ). SI PRESISTE EL ESTÍMULO Y LA CICATRIZACIÓN NO ORGANIZA LA NECROSIS SE PUEDE FORMAR ABSCESO (PUS EN UNA CAVIDAD NEOFORMADA). • 3. - PROGRESIÓN A LA CRONICIDAD : SI PERSISTE EL ESTÍMULO O LA REACCIÓN INFLAMATORIA NO SE RESUELVE ( ÚLCERA PÉPTICA GASTRODUODENAL).
ABSCESOS PULMONARES
INFLAMACIÓN AGUDA PATRONES MORFOLÓGICOS • INFLAMACIÓN SEROSA • EXUDADO LÍQUIDO CON PROTEINAS ( PLASMA). EN LAS MUCOSAS CATARRO = FLUIR HACIA FUERA). EN EL TEJIDO CELULAR SUBCUTÁNEO (HABÓN POR PICADURA DE INSECTO). EN LAS CAVIDADES ( DERRAME PLEURAL, PERICÁRDICO, ASCITIS). • INFLAMACIÓN FIBRINOSA • EXUDADO RICO EN FIBRINA. ES TÍPICA DE LAS CAVIDADES SEROSAS: PLEURA Y PERICARDIO. ASPECTO MACROSCÓPICO “COR VELLOSO” POR UREMIA (INSIFICIENCIA RENAL CRÓNICA) ARTRITIS REUMATOIDE. . ETC. EVOLUCIÓN: RESOLUCCIÓN. ORGANIZACIÓN POR TEJIDO FIBROSOCICATRIZ (SINEQUIAS). • INFLAMACIÓN PURULENTA • SUPURACIÓN = PUS (PMN + DETRITUS + LÍQUIDO PROTEICO). COCOS PIÓGENOS ETC. FLEMÓN (INFLAMACIÓN AGUDA DIFUSA). • ULCERA = DEFECTO SUPERFICIAL POR DESCAMACIÓN DE TEJIDO NECRÓTICO INFLAMATORIO. ( DIGESTIVO, PIEL PIERNA). SEUDOMEMBRANAS
DERRAME PLEURAL
DERRAME QUILOSO
PERITONITIS FIBRINOSA
EXUDADO FIBRINO-PURULENTO
PERICARDITIS FIBRINOSA
PERICARDITIS FIBRINOSA
PERICARDITIS FIBRINOSA-SINEQUIAS
SINEQUIAS PLEURALES
PERICARDITIS SUPURADA
EXUDADO PURULENTO
MENINGITIS PURULENTA
APENDICITIS AGUDA FLEMONOSA
APENDICITIS AGUDA-ÚLCERA
APENDICITIS AGUDA-DETALLE
APENDICITIS AGUDA- FLEMÓN
INFLAMACIÓN NECROTIZANTE-ÚLCERA DE ESÓFAGO
INFLAMACIÓN NECROTIZANTE-ÚLCERA GÁSTRICA
INFLAMACIÓN NECROTIZANTE-ULCERA POR DECÚBITO LARINGE
COLITIS SEUDOMEMBRANOSA
COLITIS SEUDOMEMBRANOSA
COLITIS SEUDOMEMBRANOSA. DETALLE
REPUESTAS GANGLIONAR Y GENERAL EN INFLAMACIÓN AGUDA • EL SISTEMA LINFÁTICO EN LA INFLAMACIÓN • • CONTROLA Y FILTRA LOS LÍQUIDOS EXTRAVACULARES. SEGUNDA BARRERA DE DEFENSA. LOS VASOS LINFÁTICOS PUEDEN SE AFECTADOS SECUNDARIAMENTE POR LA INFLAMACIÓN LINFANGITIS Y EXTENDER ESTA DESDE EL FOCO INFLAMATORIO. CUANDO LA INFLAMACIÓN ALCANZA LOS GANGLIOS LÍFATICOS REGIONALES SE PRODUCE LA HINCHAZÓN INFLAMATORIO LINFADENITIS. • GENERALIZACIÓN DE LA INFLAMACIÓN • CUANDO LOS GÉRMENES PASAN A LA SANGRE = BACTERIEMIA. . SON FAGOCITADOS POR SMF( HIGADO, BAZO, MÉDULA ÓSEA). SI NO ES EFICAZ LOS PATÓGENOS SE MULTIPLICAN= SEPSIS (SEPTICIEMIA). COLONIZAN Y SE ACANTONAN EN LAS VÁLVULAS CARDIACAS, RIÑON, MENINGES Y SNC, ARTICULACIONES =FOCOS DE SEPTICO-PIOHEMIA. .
FOCO DE INFECCIÓN Y TRAYECTO DE LINFANGITIS
LINFADENITIS
LINFADENITIS REACTIVA INESPECIFICA
FOCO DE SEPTICO-PIOHEMIA ENDOCARTITIS BACTERIANA
ENDOCARDITIS BACTERIANA
EFECTOS SISTÉMICOS DE LA INFLAMACIÓN AGUDA • FIEBRE: • ES UNO DE SIGNOS FUNDAMENTALES SOBRE TODO EN LA INFLAMACIONES AGUDAS INFECCIOSAS. EN LA FASE DE REACCIÓN AGUDA INTERVIENEN CAMBIOS: METABÓLICOS (PROT C REACTIVA, SAA- AMILOIDE A DEL SUERO Y AMILOIDE. P). SN AUTONÓMICO ( VASOCONSTRICIÓN CUTÁNEA, TAQUICARDIA, + TENSÍON ARTERIAL) Y FUNCIONALES (ESCALOFRIOS, MALESTAR , ETC). • LEUCOCITOSIS • • EN LAS INFECIONES BACTERIANAS SE AUMENTA LA TASA Y HAY NEUTROFILIA CON DESVIACIÓN IZQUIERDA. ALGUNAS INFECIONES PRODUCIDAS POR VIRUS (SARAPIÓN, RUBEOLA, PAROTIDIS) CURSAN CON LINFOCITOSIS. EN EL ASMA Y EN PARASITOSIS PUEDE HABER EOSINOFÍLIA. OTRAS INFECIONES (FIEBRE TIFOIDEA, ETC 9 SE ACOMPAÑAN DE LEUCOPENIA.
LEUCOCITOSIS POR POLINUCLEARES
INFLAMACIÓN AGUDA EN INFARTO DE MIOCARDIO